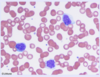
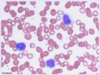
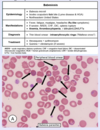

Infectious Disease I Flashcards
(65 cards)
A PPD is considered positive in HIV patients if the induration size is > […] mm.
A PPD is considered positive in HIV patients if the induration size is > 5 mm.
may be false-negative in patients with CD4+ counts < 200/mm3

Antibiotic prophylaxis in HIV patients with CD4+ count < 50/mm3 should include […] (MAC) and […] (PCP, toxoplasma).
Antibiotic prophylaxis in HIV patients with CD4+ count < 50/mm3 should include azithromycin (MAC) and TMP-SMX (PCP, toxoplasma).

How do humans typically contract an Echinococcus granulosus infection?
Consumption of food or water contaminated with dog feces
sheep are the intermediate host

How is cutaneous larva migrans typically acquired (mode of transmission)?
Walking barefoot on contaminated sand or soil

How is the diagnosis of mucormycosis established?
sinus endoscopy with biopsy & culture

In addition to empiric antibiotics, what other medication should be administered to patients with suspected bacterial meningitis?
Corticosteroids
helps prevent the neurological deficits associated with pneumococcal meningitis (e.g. deafness, focal deficits); should be discontinued if pneumococcal meningitis is ruled out
In areas with high rates of chloroquine-resistant malaria, chemoprophylaxis typically includes […], […], or […].
In areas with high rates of chloroquine-resistant malaria, chemoprophylaxis typically includes atovaquone-proguanil, doxycycline, or mefloquine
e.g. Africa, Asia (including India), and Oceania

In healthy adults, acute hepatitis B infection is self-limited in > […]% of cases.
In healthy adults, acute hepatitis B infection is self-limited in > 90-95% of cases.
In the United States, a PPD is considered negative in healthy patients with low likelihood of TB if the induration size is […].
In the United States, a PPD is considered negative in healthy patients with low likelihood of TB if the induration size is 15 mm.
the cutoff for intermediate-risk patients (e.g. healthcare workers, recent immigrants) is < 10 mm

In the United States, a PPD is considered positive in those with high risk of TB if the induration size is > […] mm (e.g. immunosuppressed patients, recent contacts of known TB case).
In the United States, a PPD is considered positive in those with high risk of TB if the induration size is > 5 mm (e.g. immunosuppressed patients, recent contacts of known TB case).

In the United States, a PPD is considered positive in those with intermediate risk of TB if the induration size is > […] mm (e.g. healthcare workers, IVDA, recent immigrants).
In the United States, a PPD is considered positive in those with intermediate risk of TB if the induration size is > 10 mm (e.g. healthcare workers, IVDA, recent immigrants).

Indications for corticosteroid use in Pneumocystis pneumonia treatment (in addition to TMP-SMX) include PaO2 […] mmHg.
Indications for corticosteroid use in Pneumocystis pneumonia treatment (in addition to TMP-SMX) include PaO2 < 70mmHg or A-a gradient > 35 mmHg.
also indicated if SaO2 < 92%

Infection with Vibrio vulnificus causes severe infection in patients who have […] disease (organ).
Infection with Vibrio vulnificus causes severe infection in patients who have liver disease (organ).
e.g. cirrhosis, hepatitis, hemochromatosis

One symptom associated with bacterial endocarditis is septic arterial or pulmonary […].
One symptom associated with bacterial endocarditis is septic arterial or pulmonary emboli.
mnemonic: FROM JANE; may cause various nodes/lesions associated with bacterial endocarditis
One symptom associated with bacterial endocarditis is […], which occurs as a result of increased release of hepcidin.
One symptom associated with bacterial endocarditis is anemia of chronic disease, which occurs as a result of increased release of hepcidin.
mnemonic: FROM JANE; ACD is a microcytic anemia with high ferritin and low serum iron
One symptom associated with bacterial endocarditis is […], which are small, nontender, erythematous lesions on the palm or sole.
One symptom associated with bacterial endocarditis is Janeway lesions, which are small, nontender, erythematous lesions on the palm or sole.
mnemonic: FROM JANE

One symptom associated with bacterial endocarditis is […], which occurs as blood flows over vegetations on the heart valve.
One symptom associated with bacterial endocarditis is murmur, which occurs as blood flows over vegetations on the heart valve.
mnemonic: FROM JANE
One symptom associated with bacterial endocarditis is […], which are tender, raised lesions on the finger or toe pads.
One symptom associated with bacterial endocarditis is Osler nodes, which are tender, raised lesions on the finger or toe pads.

One symptom associated with bacterial endocarditis is […], which are round, white spots on the retina surrounded by hemorrhage.
One symptom associated with bacterial endocarditis is Roth spots, which are round, white spots on the retina surrounded by hemorrhage.
mnemonic: FROM JANE

One symptom associated with bacterial endocarditis is […] in the nail bed.
One symptom associated with bacterial endocarditis is splinter hemorrhages in the nail bed.
mnemonic: FROM JANE; occurs due to embolization of septic vegetations
Osteomyelitis in diabetic patients is typically preceded by a long-standing foot ulcer that spreads […] to bone, causing a […]-microbial infection.
Osteomyelitis in diabetic patients is typically preceded by a long-standing foot ulcer that spreads contiguously to bone, causing a poly-microbial infection.
Patients who received blood transfusions before […] should be screened for hepatitis C.
Patients who received blood transfusions before 1992 should be screened for hepatitis C.
do you need to memorize the year? probably not… suspend this card if you want 3
Patients with HIV who present with an AIDS defining illness secondary to lack of anti-retroviral therapy should be initiated on HAART […] after treatment of the infection.
Patients with HIV who present with an AIDS defining illness secondary to lack of anti-retroviral therapy should be initiated on HAART two weeks after treatment of the infection.
to prevent immune reconstitution syndrome
Patients with suspected aspiration pneumonia should be treated with antibiotics that include […] coverage.
Patients with suspected aspiration pneumonia should be treated with antibiotics that include anaerobic coverage.
e.g. clindamycin, metronidazole + amoxicillin, amoxicillin-clavulanate